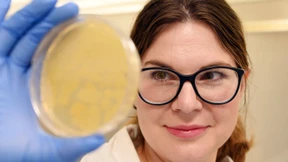
Start-up-Gründer überlegen länger

Balkonista aus Basel
Ein Start-up will mit Saatgutboxen für Nachhaltigkeit begeistern. Von Pflanzen umgeben zu sein und ihnen beim Wachsen zuzuschauen, das macht das Team glücklich.

Ein Start-up will mit Saatgutboxen für Nachhaltigkeit begeistern. Von Pflanzen umgeben zu sein und ihnen beim Wachsen zuzuschauen, das macht das Team glücklich.

Sven Weizenegger suchte einst für die Telekom nach Sicherheitslücken. Heute bringt er die deutschen Streitkräfte digital auf Trab.

Die Pandemie hat der Touristenplattform GetYourGuide schwer geschadet. Jetzt brummt das Geschäft wieder.

Der Traditionskonzern mit dem Elektroauto-Start-up: Die beiden sehr ungleichen Unternehmen gehen für ihre Transporter eine strategische Partnerschaft ein.
Französisches Fintech setzt trotz raueren Finanzierungsklimas Expansionskurs fort

Das französische Start-up Sorare und die Deutsche Fußball Liga vertiefen ihre Partnerschaft. An anderer Stelle droht dem Unternehmen Ungemach.

Miriam Weilmünster aus Bad Vilbel stellt in der Fernsehsendung „Die Höhle der Löwen“ Brustwarzenabdeckungen vor und erfüllt sich damit einen Traum. Doch nicht immer werden die Versprechen der TV-Show gehalten.

In Oestrich-Winkel sind Seiteneinsteiger, die Rheingauer Weingüter kaufen, keine Exoten. Neu ist jedoch die spannende Kombination aus Wein und Yoga, welche das Wein-Startup einzigartig macht.

Die Coronakrise hat Lebensmittellieferdiensten zu einem Hochlauf verholfen. Doch nun belasten Inflation und steigende Zinsen das Geschäft.

Das junge Unternehmen Werkules will der Zettelwirtschaft ein Ende bereiten. Die Branche muss digitaler werden – das wissen die Gründer aus eigener Erfahrung.
Die konjunkturellen Folgen des Ukrainekriegs kommen nun auch bei Start-ups an. Vor allem das Finanzierungsumfeld bereitet ihnen Sorgen.

Die Bundesregierung hat ein Eckpunktepapier für ein Zukunftsfinanzierungsgesetz vorgelegt. Ziel ist es, den deutschen Kapitalmarkt zu stärken sowie Start-ups, Wachstumsunternehmen und kleineren und mittleren Unternehmen (KMU) den Zugang zum Kapitalmarkt im Rahmen eines Börsengangs (Initial Public Offering – IPO) und die Aufnahme von Eigenkapital zu erleichtern. Auch wenn das Papier einige gute Punkte enthält, greift es zu kurz.

Aktive und ehemalige Sportler treten heute gern als Investoren auf. Ein Beispiel ist Mario Götze, der Schütze zum Siegestreffer im Fußball-WM-Finale 2014.

Der Hoffnungsträger der Briten für eine Elektroautoindustrie scheint in Schwierigkeiten zu stecken. Die Erwartungen für eine neue Finanzierungsrunde sinken.

Medizinprodukte können das Leben mancher Patienten drastisch erleichtern – doch teils lassen sich Implantate nach ein paar Jahren nicht mehr nutzen und Gesetze schützen nicht vor Supportausfall.
Fast jedes zweite Start-up bezahlt seine Mitarbeiter mit Aktien

Elon Musks Raumfahrtunternehmen SpaceX hat eine Allianz mit T-Mobile geschlossen, um Handy-Empfang aus dem All in entlegene Regionen zu bringen.

Nur sieben Prozent der befragten Start-ups können sich nicht vorstellen, ihre Angestellten am Erfolg des Unternehmens zu beteiligen.

Deutschland hat ein Energie-Problem, Tesvolt eine Lösung. Das Unternehmen aus Wittenberg baut Batterien im XXL-Format.

Ein britisches Start-up tritt in den deutschen Markt ein, um günstige Auslandsüberweisungen auch bei höheren Beträgen zu ermöglichen. Doch die Konkurrenz ist groß – nicht zuletzt wegen der EU-Regulierung.

Yilin Liao erwirbt den Master of Finance an der Frankfurt School of Finance and Management. Seine Art der Studienfinanzierung ist ungewöhnlich.

In Traditionskonzernen Innovationen einzuführen, ist mühsam. Der designierte Vorstandschef des Baukonzerns Strabag aber setzt auf Ideen von Start-ups.

Für die Fahrt mit vielen Zügen und Bussen soll eine Buchung genügen – das will Omio ermöglichen. Dass das Ziel noch unerreicht blieb, liege auch an der Bahn. Sogar das Kartellamt ist eingeschaltet.

Das unrühmliche Ende bei Wework hat Adam Neumann nicht von einem neuen Anlauf als Unternehmer abgehalten. Dafür hat er sich eine üppige Investition gesichert. Aus Deutschland kommt heftige Kritik.

Ein Embryo entsteht quasi aus dem Nichts – oder ein Homunkulus? Mit Kunstembryonen sollen Organfabriken entstehen. Stammzellforscher in Israel und den USA haben die Embryozüchtung spektakulär vorangetrieben.

Die Debatte um weitere Entlastungen in der Energiekrise läuft. Einer Erzfeindin von Donald Trump droht eine Niederlage. Und Menschen über 60 Jahren soll eine weitere Corona-Impfung empfohlen werden. Der F.A.Z.-Newsletter.
Ländliche Regionen schneiden bei Neugründungen von Start-ups schlecht ab. Das bietet erhebliches Spaltungspotenzial.
Erstmals seit Langem geht die Zahl der neu gegründeten Start-ups zurück, zeigt eine neue Studie. Doch es gibt Lichtblicke – regional und in einzelnen Branchen.

Arbeitskräfte sind knapp, und so nehmen frühere Chefs oft Mitarbeiter mit Kusshand zurück, die berufliche Ausflüge anderswohin gemacht haben. Warum der ehemalige Arbeitgeber eine gute Option sein kann, wenn die neue Stelle enttäuscht.

Das kleine Frankfurter Start-up Otto ID soll für den Nasdaq-Konzern Cintas die Abläufe in Großwäschereien digitalisieren und optimieren. Für Gründer Karsten Otto liegt die ungewöhnliche Zusammenarbeit nahe.

Co-Working liegt im Trend. Aber wie geht es wirklich zu in einem Co-Working-Space mit stylischen Büromöbeln, unbekannten Kollegen und schlecht eingeräumter Spülmaschine? Ein Erfahrungsbericht.

Ein Smoothie aus zeitgenössischem Garnichts: Emily Segal hat eine „fiktionale Ethnographie“ der Start-up-Welt geschrieben. „Rückläufiger Merkur“ lebt stärker von seinen Beschreibungen, als dass es eine durchdachte Erzählung wäre.

Auf der internationalen Leitmesse für Computergrafiken zeigen auch Start-ups aus Darmstadt, wie sie die digitale Zukunft gestalten wollen.

Serena Williams wird ihre Karriere als eine der Top-Verdienerinnen im Tennis beenden. Künftig will sie sich auf unternehmerische Projekte konzentrieren.
Autismus-Störungen sind sehr individuell. Kulturen aus Nervenzellen von Patienten sollen der Frankfurter Uniklinik dabei helfen, die Behandlung zu verbessern.

Doch es gibt auch Hindernisse, die auf Jungunternehmen warten. Bürokratie ist nur eines davon. Sorgen bereitet unter anderem die finanzielle Situation.